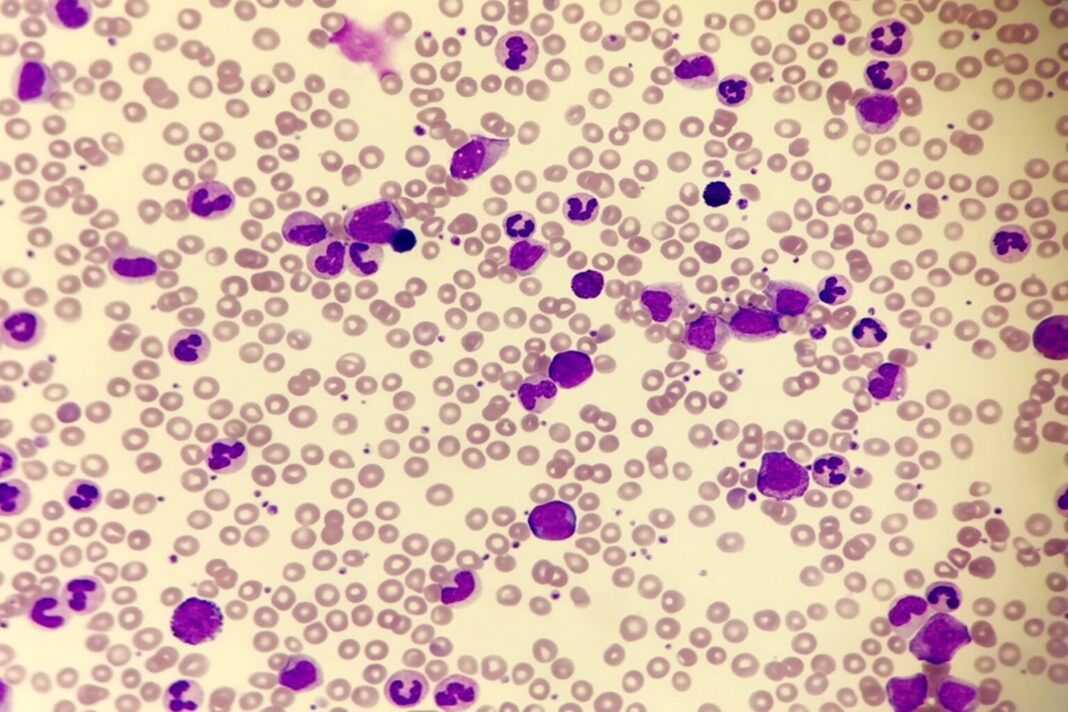

Το azacitidine σε δισκία είναι η πρώτη στην Ευρωπαϊκή Ένωση αρχική θεραπεία συντήρησης, για ασθενείς με διαφορετικούς υποτύπους της οξείας μυελογενούς λευχαιμίας. Στο πλαίσιο της πιλοτικής μελέτης QUAZAR® AML-001, το azacitidine βελτίωσε σημαντικά τη συνολική επιβίωση και την επιβίωση χωρίς υποτροπή της νόσου
σε ασθενείς με ΟΜΛ.

Η Bristol Myers Squibb ανακοίνωσε πρόσφατα ότι η Ευρωπαϊκή Επιτροπή χορήγησε πλήρη άδεια κυκλοφορίας για το azacitidine σε δισκία ως θεραπεία συντήρησης σε ενηλίκους ασθενείς με οξεία μυελογενή λευχαιμία (ΟΜΛ), οι οποίοι πέτυχαν πλήρη ύφεση (CR) ή πλήρη ύφεση με ατελή αιματολογική ανάκαμψη (CRi) ύστερα από θεραπεία εφόδου σε συνδυασμό με ή χωρίς αγωγή σταθεροποίησης. Οι ασθενείς αυτοί δεν είναι υποψήφιοι για μεταμόσχευση αρχέγονων αιμοποιητικών κυττάρων (HSCT) ή επιλέγουν να μην προχωρήσουν σε μεταμόσχευση. Το azacitidine σε δισκία είναι η πρώτη αρχική θεραπεία συντήρησης, χορηγούμενη από του στόματος άπαξ ημερησίως, η οποία καταδεικνύει αφενός σημαντική συνολική επιβίωση και αφετέρου όφελος ως προς την επιβίωση χωρίς υποτροπή της νόσου σε ασθενείς που πάσχουν από διαφορετικούς υποτύπους της ΟΜΛ.
Η κεντρική άδεια κυκλοφορίας εγκρίνει τη χρήση του azacitidine στο σύνολο των κρατών μελών της Ευρωπαϊκής Ένωσης, καθώς και στη Νορβηγία, στην Ισλανδία και στο Λιχτενστάιν.* Επιπλέον, το azacitidine έχει εγκριθεί στις Ηνωμένες Πολιτείες για τη συνέχιση της θεραπείας ενηλίκων ασθενών με ΟΜΛ οι οποίοι πέτυχαν πρώτη πλήρη ύφεση (CR) ή πλήρη ύφεση με ατελή αιματολογική ανάκαμψη (CRi) ύστερα από εντατική χημειοθεραπεία εφόδου και οι οποίοι δεν είναι σε θέση να ολοκληρώσουν εντατική θεραπεία με στόχο την ίαση. Στον Καναδά, το azacitidine έχει λάβει έγκριση ως θεραπεία συντήρησης για ενήλικες ασθενείς με ΟΜΛ οι οποίοι πέτυχαν πλήρη ύφεση (CR) ή πλήρη ύφεση με ατελή αιματολογική ανάκαμψη (CRi) ύστερα από θεραπεία εφόδου σε συνδυασμό με ή χωρίς αγωγή σταθεροποίησης και οι οποίοι δεν είναι κατάλληλοι για μεταμόσχευση αρχέγονων αιμοποιητικών κυττάρων (HSCT).
Ακάλυπτη η θεραπεία για την μυελογενή λευχαιμία
- «Η ανάγκη για επιλογές θεραπείας συντήρησης για την οξεία μυελογενή λευχαιμία παραμένει ακάλυπτη στην Ευρωπαϊκή Ένωση, εάν λάβουμε υπόψη ότι η ανταπόκριση στη θεραπεία εφόδου ενδέχεται να είναι μικρής διάρκειας και ο κίνδυνος υποτροπής είναι υψηλός, ιδιαίτερα για ασθενείς που δεν κρίνονται κατάλληλοι για μεταμόσχευση αρχέγονων κυττάρων», δήλωσε ο Andrew Wei, MBBS, Ph.D., κύριος ερευνητής της μελέτης QUAZAR® AML-001 στο Νοσοκομείο Alfred και το Πανεπιστήμιο Monash στη Μελβούρνη της Αυστραλίας. «Η έγκριση του azacitidine σε δισκία από την Ευρωπαϊκή Επιτροπή έχει τη δυνατότητα να προσφέρει κλινικό όφελος και να αλλάξει το θεραπευτικό παράδειγμα για ασθενείς με διαφορετικούς υποτύπους της νόσου».

Έγκριση από Ευρωπαϊκή Ένωση
- Η έγκριση του azacitidine σε δισκία από την Ευρωπαϊκή Επιτροπή βασίστηκε σε αποτελέσματα από τη μελέτη QUAZAR® AML-001, μία διεθνή, τυχαιοποιημένη, διπλά τυφλή μελέτη Φάσης 3. Οι ασθενείς που κρίθηκαν κατάλληλοι ήταν ηλικίας 55 ή άνω, είχαν πρόσφατα διαγνωσθεί με ΟΜΛ, παρουσίαζαν ευρήματα κυτταρογενετικής ανάλυσης ενδιάμεσου ή υψηλού κινδύνου, είχαν πετύχει πρώτη πλήρη ύφεση (CR) ή πλήρη ύφεση με ατελή αιματολογική ανάκαμψη (CRi) ύστερα από εντατική χημειοθεραπεία εφόδου σε συνδυασμό με ή χωρίς αγωγή σταθεροποίησης (της επιλογής του ερευνητή πριν από την ένταξη στη μελέτη) και δεν ήταν υποψήφιοι για μεταμόσχευση αρχέγονων αιμοποιητικών κυττάρων (HSCT) κατά τη διαλογή.
- «Η έγκριση του azacitidine σε δισκία αποτελεί σημαντική θεραπευτική εξέλιξη για τους ασθενείς στην Ευρωπαϊκή Ένωση που ζουν με οξεία μυελογενή λευχαιμία και συνεχίζουν να χρειάζονται επειγόντως θεραπείες συντήρησης για αυτήν την επιθετική μορφή αιματολογικού καρκίνου», δήλωσε ο Noah Berkowitz, M.D., Ph.D., ανώτερος αντιπρόεδρος ανάπτυξης του τομέα Αιματολογίας της Bristol Myers Squibb. «Έχουμε δεσμευτεί να συμβάλλουμε στη βελτίωση των μακροχρόνιων αποτελεσμάτων και τη σημαντική παράταση της επιβίωσης για ασθενείς που πάσχουν από δύσκολα στην αντιμετώπιση νοσήματα. Παράλληλα, συνεργαζόμαστε με τα κράτη μέλη της Ευρωπαϊκής Ένωσης προκειμένου το azacitidine σε δισκία να γίνει διαθέσιμο στους υποψήφιους ασθενείς το συντομότερο δυνατό».
- *Η κεντρική άδεια κυκλοφορίας δεν περιλαμβάνει έγκριση στη Μεγάλη Βρετανία (Αγγλία, Σκωτία και Ουαλία).
Σχετικά με τη μελέτη QUAZAR® AML-001
- Η μελέτη QUAZAR® AML-001 είναι μία παγκόσμια, τυχαιοποιημένη, διπλά τυφλή μελέτη Φάσης 3. Οι ασθενείς που κρίθηκαν κατάλληλοι ήταν ηλικίας 55 ή άνω, είχαν πρόσφατα διαγνωσθεί με ΟΜΛ, παρουσίαζαν ευρήματα κυτταρογενετικής ανάλυσης ενδιάμεσου ή υψηλού κινδύνου, είχαν πετύχει πρώτη πλήρη ύφεση (CR) ή πλήρη ύφεση με ατελή αιματολογική ανάκαμψη (CRi) ύστερα από εντατική χημειοθεραπεία εφόδου σε συνδυασμό με ή χωρίς αγωγή σταθεροποίησης (της επιλογής του ερευνητή πριν από την ένταξη στη μελέτη) εντός τεσσάρων μηνών (+/- 7 ημέρες) πριν την τυχαιοποίηση και δεν ήταν υποψήφιοι για μεταμόσχευση αρχέγονων αιμοποιητικών κυττάρων (HSCT) κατά τη διαλογή. Στη μελέτη εντάχθηκαν 472 ασθενείς, οι οποίοι κατανεμήθηκαν τυχαία (τυχαιοποιήθηκαν 1:1) ώστε να λάβουν είτε azacitidine 300 mg (N=238) είτε εικονικό φάρμακο (N=234), από του στόματος άπαξ ημερησίως, για 14 ημέρες κατά τη διάρκεια ενός κύκλου θεραπείας 28 ημερών, σε συνδυασμό με βέλτιστη υποστηρικτική αγωγή. Επίσης, αποτελέσματα από τη μελέτη δημοσιεύθηκαν στο ιατρικό περιοδικό New England Journal of Medicine τον Δεκέμβριο του 2020.*
- Στο σκέλος θεραπείας με azacitidine, η διάμεση συνολική επιβίωση (OS), που ήταν και το πρωτεύον καταληκτικό σημείο της μελέτης, ξεπέρασε τα δύο χρόνια από τη χρονική στιγμή της τυχαιοποίησης (24,7 μήνες• 95% Διάστημα Εμπιστοσύνης [CI]: 18,7 έως 30,5) σε σύγκριση με 14,8 μήνες για το εικονικό φάρμακο (Λόγος Κινδύνου [HR]: 0,69, 95% CI: 0,55 έως 0,86• p=0,0009). Η διάμεση διάρκεια θεραπείας ήταν 12 κύκλοι (1 έως 82) για το azacitidine και 6 κύκλοι για το εικονικό φάρμακο (1 έως 76). Επιπλέον, η διάμεση επιβίωση χωρίς υποτροπή ήταν σημαντικά μεγαλύτερη με το azacitidine σε σύγκριση με το εικονικό φάρμακο (10,2 μήνες και 4,8 μήνες, αντίστοιχα• p<0,001). Η συνολική ποιότητα ζωής των ασθενών διατηρήθηκε κατά τη διάρκεια της θεραπείας με azacitidine.
- Οι πιο συχνές ανεπιθύμητες ενέργειες και στα δύο σκέλη θεραπείας ήταν Βαθμού 1 ή 2 και αφορούσαν στο γαστρεντερικό σύστημα. Συχνές ανεπιθύμητες ενέργειες Βαθμού 3 ή 4 ήταν η ουδετεροπενία (στο 41% των ασθενών που έλαβαν θεραπεία με azacitidine και στο 24% των ασθενών που έλαβαν εικονικό φάρμακο) και η θρομβοπενία (22% και 21%, αντίστοιχα).
- *Μεμονωμένα αποτελέσματα που συνδέονται με τις ρυθμιστικές αρχές ενδέχεται να διαφέρουν από τα αποτελέσματα που περιλαμβάνονται στη δημοσίευση.

Σχετικά με την οξεία μυελογενή λευχαιμία
- Η οξεία μυελογενής λευχαιμία (ΟΜΛ) αποτελεί μία από τις πιο συχνές μορφές οξείας λευχαιμίας σε ενήλικες. Η συχνότητα της νόσου υπολογίζεται σε περισσότερες από 350.000 περιπτώσεις παγκοσμίως, ενώ το εκτιμώμενο ποσοστό πενταετούς επιβίωσης για την ΟΜΛ στην Ευρώπη αγγίζει το 17%. Η ΟΜΛ χαρακτηρίζεται από τον ταχύ πολλαπλασιασμό μη φυσιολογικών κυττάρων στον μυελό των οστών, οδηγώντας σε μη φυσιολογική παραγωγή και λειτουργία των κυττάρων του αίματος. Λόγω της μειωμένης παραγωγής ερυθρών αιμοσφαιρίων, αιμοπεταλίων και λευκών αιμοσφαιρίων, οι ασθενείς μπορεί να εμφανίζουν αναιμία, αιμορραγίες και λοιμώξεις. Η ΟΜΛ είναι μία ετερογενής νόσος που συνδέεται με ποικίλες γενετικές μεταλλάξεις και, εάν δεν αντιμετωπιστεί έγκαιρα, μπορεί να παρουσιάσει ταχεία εξέλιξη και να οδηγήσει τον ασθενή στον θάνατο.
- Η ανταπόκριση των ασθενών στη θεραπεία μπορεί να είναι μικρής διάρκειας. Αυτό σημαίνει ότι μετά την αρχική ανταπόκριση στη χημειοθεραπεία, περίπου οι μισοί εμφανίζουν υποτροπή εντός ενός έτους, αναδεικνύοντας τη σημαντική ακάλυπτη ανάγκη για θεραπείες συντήρησης που παρατείνουν τη συνολική επιβίωση.
Σχετικά με το azacitidine
- Το azacitidine σε δισκία, η πρώτη αρχική θεραπεία συντήρησης που εγκρίθηκε στην Ευρωπαϊκή Ένωση για ασθενείς με διαφορετικούς υποτύπους οξείας μυελογενούς λευχαιμίας, είναι ένας υπομεθυλιωτικός παράγοντας, χορηγούμενος από του στόματος άπαξ ημερησίως, ο οποίος ενσωματώνεται στο DNA και το RNA. Ο βασικός μηχανισμός δράσης θεωρείται ότι είναι η υπομεθυλίωση του DNA, καθώς και η άμεση κυτταροτοξικότητα έναντι μη φυσιολογικών αιμοποιητικών κυττάρων του μυελού των οστών. Η υπομεθυλίωση μπορεί να αποκαταστήσει τη φυσιολογική λειτουργία γονιδίων που είναι κρίσιμης σημασίας για τη διαφοροποίηση και τον πολλαπλασιασμό των κυττάρων. Το azacitidine έχει εγκριθεί στις ΗΠΑ για τη συνέχιση της θεραπείας ενηλίκων ασθενών με οξεία μυελογενή λευχαιμία που πέτυχαν πρώτη πλήρη ύφεση (CR) ή πλήρη ύφεση με ατελή αιματολογική ανάκαμψη (CRi) ύστερα από εντατική χημειοθεραπεία εφόδου και οι οποίοι δεν είναι σε θέση να ολοκληρώσουν εντατική θεραπεία με στόχο την ίαση. Επίσης, το azacitidine είναι εγκεκριμένο στον Καναδά ως θεραπεία συντήρησης για ενήλικους ασθενείς με οξεία μυελογενή λευχαιμία (ΟΜΛ) που πέτυχαν πλήρη ύφεση (CR) ή πλήρη ύφεση πλήρη ύφεση με ατελή αιματολογική ανάκαμψη (CRi) ύστερα από θεραπεία εφόδου σε συνδυασμό με ή χωρίς αγωγή σταθεροποίησης και οι οποίοι δεν είναι κατάλληλοι για μεταμόσχευση αρχέγονων αιμοποιητικών κυττάρων (HSCT).
Bristol Myers Squibb: Δημιουργώντας ένα καλύτερο μέλλον για τα άτομα με καρκίνο
- Στη Bristol Myers Squibb μας εμπνέει ένα μοναδικό όραμα — να αλλάζουμε τη ζωή των ασθενών αξιοποιώντας την επιστήμη. Στόχος της έρευνας που διεξάγουμε για τη θεραπεία του καρκίνου είναι να παρέχουμε φάρμακα που δίνουν σε κάθε ασθενή τη δυνατότητα να ζήσει μια καλύτερη, υγιή ζωή, έχοντας αυξημένες πιθανότητες ίασης. Με τη σημαντική επιστημονική τεχνογνωσία μας και τις πρωτοποριακές πλατφόρμες ανακάλυψης νέων μορίων, διερευνούμε εις βάθος κάθε πτυχή του καρκίνου και εξερευνούμε νέους ορίζοντες στην εξατομικευμένη ιατρική, αναπτύσσοντας θεραπείες που αλλάζουν το προσδόκιμο επιβίωσης για πολλούς ασθενείς. Αναγνωρίζοντας ότι ο καρκίνος επηρεάζει με πολλούς τρόπους τη ζωή των ασθενών, έχουμε δεσμευτεί να ανταποκρινόμαστε σε κάθε πτυχή της υγειονομικής φροντίδας τους, από τη διάγνωση έως την επιβίωση. Στη Bristol Myers Squibb εργαζόμαστε για να προσφέρουμε σε όλους τους ανθρώπους που πάσχουν από καρκίνο, τη δυνατότητα να έχουν ένα καλύτερο μέλλον.

Σχετικά με τη Bristol Myers Squibb
- Η Bristol Myers Squibb είναι μια παγκόσμια βιοφαρμακευτική εταιρεία, με αποστολή να ανακαλύπτει, να αναπτύσσει και να παρέχει καινοτόμα φάρμακα που συμβάλλουν στην αποτελεσματική αντιμετώπιση σοβαρών ασθενειών. Για περισσότερες πληροφορίες σχετικά με την Bristol Myers Squibb, επισκεφθείτε την ιστοσελίδα www.bms-greece.gr. Οι εταιρίες Celgene και Juno Therapeutics είναι θυγατρικές εταιρίες που ανήκουν εξολοκλήρου στη Bristol-Myers Squibb Company. Σε ορισμένες χώρες εκτός των Ηνωμένων Πολιτειών, εξαιτίας της τοπικής νομοθεσίας, η Celgene και η Juno Therapeutics αναφέρονται ως Celgene, μια εταιρεία της Bristol Myers Squibb και Juno Therapeutics, μια εταιρεία της Bristol Myers Squibb.
Δήλωση προοπτικών της Bristol Myers Squibb
- Αυτό το δελτίο τύπου περιέχει «δηλώσεις που αφορούν μελλοντικές εξελίξεις», υπό την έννοια του Μεταρρυθμιστικού νόμου περί αγωγών ιδιωτικών χρεογράφων (Private Securities Litigation Reform Act) του 1995, που αφορούν την έρευνα, την ανάπτυξη και την εμπορική διάθεση φαρμακευτικών προϊόντων. Όλες οι δηλώσεις που δεν αφορούν σε ιστορικά γεγονότα είναι ή μπορεί να θεωρηθούν δηλώσεις που αφορούν μελλοντικές εξελίξεις. Αυτές οι δηλώσεις προοπτικών βασίζονται στις ιστορικές επιδόσεις και στις τρέχουσες προσδοκίες και προβλέψεις για τα μελλοντικά οικονομικά αποτελέσματα, τους στόχους, τα σχέδια και τους σκοπούς της εταιρείας και ενέχουν εγγενείς κινδύνους, παραδοχές και αβεβαιότητες, συμπεριλαμβανομένων εσωτερικών ή εξωτερικών παραγόντων, που θα μπορούσαν να επιφέρουν καθυστέρηση, απόκλιση ή μεταβολή σε οποιοδήποτε από αυτά στα προσεχή έτη, που είναι δύσκολο να προβλεφθούν, που ενδέχεται να είναι πέρα από τον έλεγχό μας και να οδηγήσουν σε σημαντική διαφοροποίηση των μελλοντικών οικονομικών αποτελεσμάτων, των στόχων, των σχεδίων και των σκοπών της εταιρείας από αυτά που εκφράζονται ρητώς ή εμμέσως από τις δηλώσεις. Σε αυτούς τους κινδύνους, τις παραδοχές, τις αβεβαιότητες και τους λοιπούς παράγοντες περιλαμβάνονται, μεταξύ άλλων, ότι η έκβαση των διαπραγματεύσεων αναφορικά με την τιμή και την αποζημίωση του azacitidine σε μεμονωμένες χώρες της Ευρώπης ενδέχεται να καθυστερήσουν ή να περιορίσουν την πιθανή εμπορική διάθεση του για την πρόσθετη ένδειξη η οποία περιγράφεται στο παρόν δελτίο Τύπου, ότι η διαρκής έγκριση αυτού του προϊόντος για την πρόσθετη ένδειξη η οποία περιγράφεται στο παρόν δελτίο Τύπου εξαρτάται από την επαλήθευση και περιγραφή των κλινικών πλεονεκτημάτων σε δοκιμές πιστοποίησης και το κατά πόσον η πρόσθετη ένδειξη η οποία περιγράφεται στο παρόν δελτίο Τύπου θα είναι εμπορικά επιτυχημένη. Δεν μπορεί να υπάρξει εγγύηση σε σχέση με δηλώσεις που αφορούν μελλοντικές εξελίξεις. Οι δηλώσεις περί μελλοντικών εξελίξεων στο παρόν δελτίο τύπου θα πρέπει να αξιολογούνται μαζί με τους πολλούς αστάθμητους παράγοντες που επηρεάζουν τις εργασίες της Bristol Myers Squibb, ιδιαίτερα εκείνους που αναγνωρίζονται στην προειδοποιητική ανάλυση παραγόντων στην Ετήσια Αναφορά της Bristol Myers Squibb στο Έντυπο 10-K για το έτος που έληξε στις 31 Δεκεμβρίου 2020, όπως επικαιροποιήθηκε από τις επακόλουθες Τριμηνιαίες της Αναφορές στο Έντυπο 10-Q, τις Τρέχουσες Αναφορές στο Έντυπο 8-K και στις άλλες εκθέσεις της εταιρείας στην Επιτροπή Κεφαλαιαγοράς. Οι δηλώσεις περί μελλοντικών εξελίξεων που περιλαμβάνονται στο παρόν έγγραφο πραγματοποιούνται κατά την ημερομηνία του παρόντος εγγράφου και, εκτός αν άλλως απαιτείται από την ισχύουσα νομοθεσία, η Bristol Myers Squibb δεν αναλαμβάνει καμία υποχρέωση να επικαιροποιεί ή να αναθεωρεί δημόσια οποιαδήποτε δήλωση περί μελλοντικών εξελίξεων λόγω νέων πληροφοριών, μελλοντικών γεγονότων, αλλαγής συνθηκών ή για άλλο λόγο.